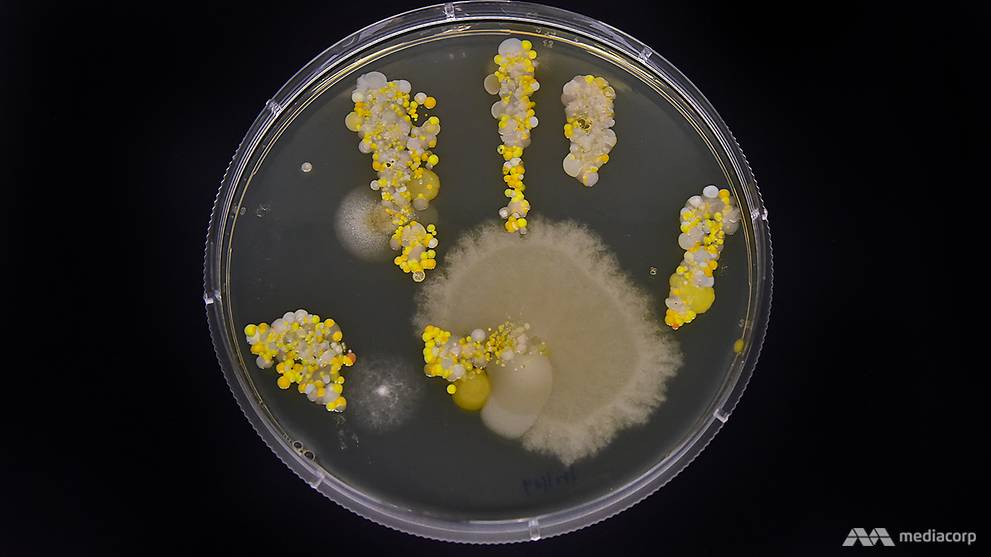
In pictures: The bacteria living on your hands right now - CNA

How to decorate your home: Tips for creating a stylish, functional space Decorating your home can be a fun and rewarding experience, but it can also be daunting. Whether you’re starting from scratch or just looking to update your existing space, these tips will help you create a stylish, functional space.
Start with the basics. When decorating your home, it’s important to start with the basics—walls, flooring, and furniture. These are the areas that will see the most use and should therefore be designed with function in mind. Choose materials that will last and be easy to care for.
Use natural elements. When decorating your home, try to use natural elements as much as possible. This will add character and interest to your space while also being Eco-friendly!
Think about storage solutions.
looking for G502 Proteus Core: Configuring Pointer Settings in On-Board Memory Mode you’ve came to the right place. We have 9 Pictures about G502 Proteus Core: Configuring Pointer Settings in On-Board Memory Mode like G502 Proteus Core: Configuring Pointer Settings in On-Board Memory Mode, Space Expo to feature NASA astronaut - masslive.com and also 35 Positive Statements for Optimal Health and Wellness. Here it is:
G502 Proteus Core: Configuring Pointer Settings In On-Board Memory Mode

Source: youtube.com
g502 settings proteus.
How to choose the right how to: What considerations should be made? Choosing the right how to can be a daunting task. There are a lot of factors to consider, such as price, features, and ease of use. Here are some tips to help you choose the right how to for your needs. Start by considering what you want your how to to do. What tasks will it be used for? Do you need it for basic home repairs or do you need something more specialized? Once you know what you need, look at the different how to options available and decide on one that closely matches your needs.
Next, consider your budget. How much money are you willing to spend? What features are important to you? Is a how to with more features worth the extra cost?
35 Positive Statements For Optimal Health And Wellness

Source: lovingessentialoils.com
positive statements wellness health optimal.
What is the goal of this guide? The goal of this guide is to provide a step-by-step guide on how to achieve personal productivity. By following these simple tips, you will be able to better focus on your tasks and improve your overall work efficiency.
How To Make A Sweet Looking XBOX Live Bio (Tutorial) - YouTube

Source: youtube.com
xbox bio.
How to make a how-to easier Making a how-to easier can be done in a variety of ways. One way is to break the how-to down into smaller, more manageable steps. Another way is to include pictures or diagrams to help illustrate the steps. And finally, it can also be helpful to provide step-by-step instructions with accompanying screenshots or videos. By taking these simple steps, users will be able to make their how-to more user-friendly and easier to follow.
Online Check-in - Webjet

Source: webjet.com.au
webjet confirmation check booking reference email number manage found flights logging profile.
What is how to and what are its benefits? How to is a guide on how to do something. It can be anything from how to make a cake, how to knit a sweater, how to drive a car, or even how to fix your computer. There are many benefits of learning how to. For one, it can help you become more efficient and proficient in certain tasks. Additionally, learning how to can make you smarter and better at problem-solving. If you want to improve your skills but don’t know where to start, try searching for How To guides online or in your local library.
Cork Oak | Rainforest Alliance

Source: rainforest-alliance.org
heliconia species.
How to entertain guests When hosting a party, it can be difficult to come up with something fun and interesting for guests to do. Here are some ideas to help you entertain them:
- Have a pool or game room ready if there is enough space. This will allow guests to take breaks from talking and socializing, and get some exercise too!
- Bring along some games, puzzles, or other activities that can be enjoyed in small groups. This will keep everyone engaged and happy.
- Serve snacks and drinks in attractive containers that can be used as conversation starters. Providing interesting tidbits about the food or drink will keep guests interested while they munch!
- Plan ahead by stocking the fridge with easy-to-make hors d’oeuvres like cheese plates, dip bowls, and fruit skewers.
Brunei Darussalam And The IMF
Source: imf.org
brunei darussalam imf.
Conclusion: what does this all mean for you? There are a few takeaways from the data that is available for us to review. First and foremost, we can see that there is no single answer to whether or not a person will be successful in their weight loss goals. However, some general guidelines do exist which can help individuals on their way to reaching their desired outcome. Secondly, it is also important to remember that weight loss results vary greatly from one individual to the next. This means that even if you follow all of the recommended tips and techniques, you may still not see the same level of success as someone else who has tried the same thing. The last conclusion we can draw from this data is that it is always important to keep working hard on your weight loss journey, as even small changes can lead to big improvements over time.
In Pictures: The Bacteria Living On Your Hands Right Now - CNA
Source: channelnewsasia.com
bacteria hands plate living cna.
How to make a home cooked meal Making a home cooked meal can be a fun and easy way to show your loved ones that you care. Here are 8 easy steps to help you get started:
- Pick an recipe or gather some ideas from recipes you have already tried.
- Decide what ingredients you will need and begin gathering them together.
- Measure out the ingredients and begin preparing them according to the recipe instructions.
- Once everything is ready, cook the meal according to the specified time frame or until it is done cooking.
- Serve the meal hot and enjoy!
Space Expo To Feature NASA Astronaut - Masslive.com

Source: masslive.com
tanner astronaut nasa joe joseph space expo feature former masslive missions flew shuttle astronauts journalinquirer.
Promoting Your Blog: Tips on how to promote your blog. How to Promote Your Blog: Tips and Advice There are a few things you can do to promote your blog and increase its visibility. Here are some tips: -Make sure your blog’s name is easy to remember. Try to find a catchy title that reflects the content of your blog. -Submit your blog to popular social media platforms, such as Twitter and Facebook. Post about new posts, give away free resources, or answer questions from followers. -Create an RSS feed for your blog and include links in your posts. This will allow readers to subscribe to updates without having to visit your website every time. -Share your blog on other websites and forums. This will help you reach a wider audience, as well as potential advertisers who may be interested in reaching this audience.
Homeworld Concept Art PART I - YouTube

Source: youtube.com
homeworld concept.
Conclusion: What was learned and what needs to be done next What was learned from this investigation? The key takeaways for this investigation are as follows:
- There is a need for more education on the topic of sexual consent.
- The way that the sexual assault case was handled highlights the need for better communication and coordination between various departments within the university.
- More needs to be done to combat sexual assault on college campuses, both in terms of prevention and response.
- There is a need for better policing mechanisms to deter and punish sexual assault perpetrators.
- More resources should be allocated to support victims of sexual assault.
- It is important to have a good victim-support system in place so that survivors can feel comfortable coming forward and receive the appropriate help.